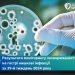
За тиждень майже 70 черкащан захворіли на гострі кишкові інфекції — Новости Черкасс

30 вересня 2024, 14:04
Другий рік поспіль я веду Ретрофест. Чистої води свято серця для мене.
Люди без особливого досвіду в організації подій роблять у невеличкому селі Озірне Водяницької громади захід, що збирає сотні людей, – пише в «Фейсбуці» відома ведуча Ольга Касьянова

«Треба щось робити, щоб зібрати на 3 БПлА для захисників з громади. Мета була 270 000 грн. Ми зібрали 280 000», – інформує Ольга.
Фото з ФБ Ольги Касьянової
 львівськиЙ
львівськиЙ